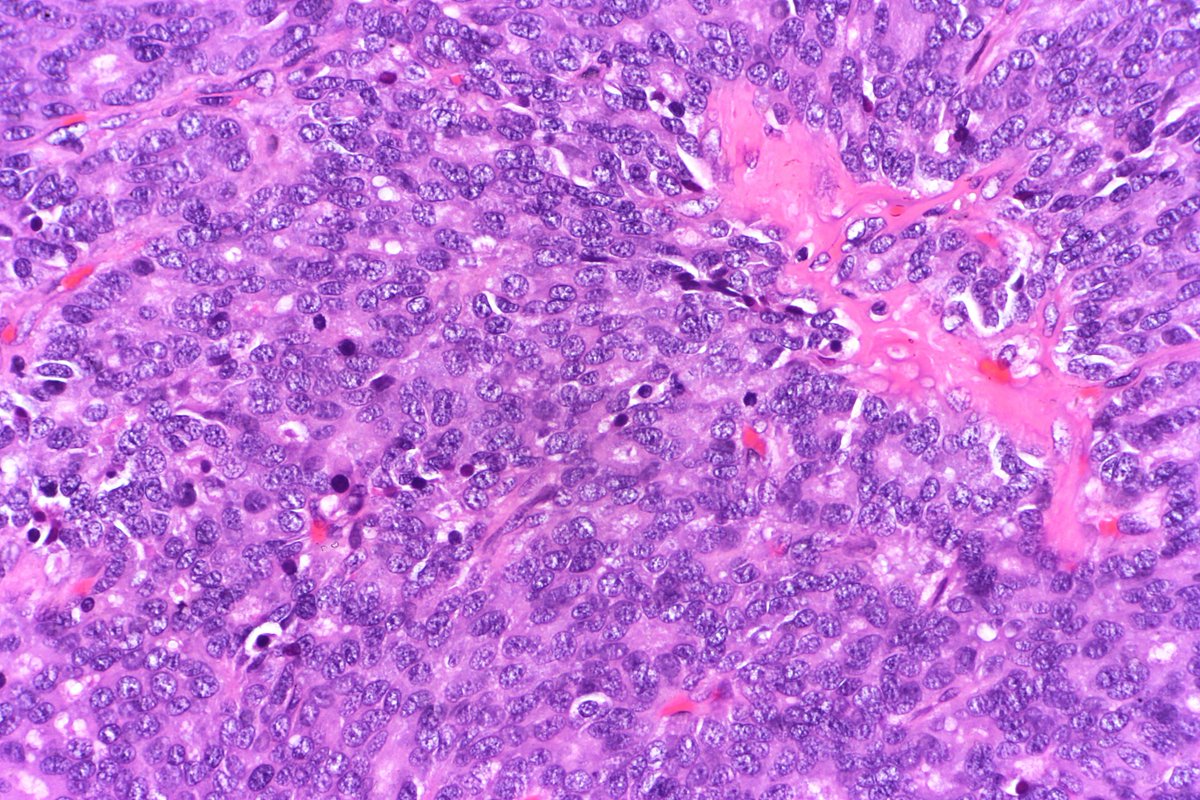
CoRus13 tweet media

CoRus13
349 posts

CoRus13
@Rus13Co
I'm a pathology resident and I'll be posting micrographs of cases that I encounter in my daily routine. You can use my pictures however you wish.
가입일 Kasım 2018
419 팔로잉915 팔로워

@Rus13Co Dear Dr:
Can we use this picture as well for type B2 thymoma? It is really nice. Thank you very much.
English

Type B2 Thymoma showing prominent large epithelial cells admixed with numerous lymphocytes. #pathology #PulmPath




English

@Rus13Co Sorry to bother you again. Just wondering can we use this picture in our book? Thank you very much.
English

Atypical carcinoid of the lung exhibiting endobronchial growth, increased mitotic activity was seen (2-10 per 10 HPF). #pathology #PulmPath

English



Pancreatobiliary-type adenocarcinoma lymph node metastasis showing well-formed, irregular glands associated with desmoplastic stroma. #pathology #GIPath




English



Fetal testis (14 weeks) showing primitive tubules with germ cells surrounded by interstitial Leydig cells. #pathology #pedipath




English

@DrGeeONE @SansanoValero Didn't know that 😀 Thanks for the up to date info!
English

@SansanoValero @Rus13Co Caeseation is only seen grossly..."necrotizing" is microscopic correlate 😁
English














































